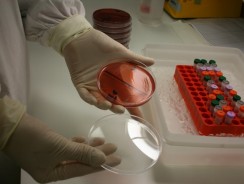

Unfortunately, many Aboriginal and Torres Strait Islander children face chronic ear infections, respiratory problems, anaemia, skin sores and other health issues in their earliest years.
Not only do these medical problems have a direct impact on a child’s health, they also affect their ability to grow, develop and learn.
Our work investigates how we can improve the health of Aboriginal and Torres Strait Islander children so they can have the best start in life.
-

Anaemia
In the NT, 15% of pregnant women and up to 25% of children aged 0-5 years are anaemic.
-

-

Child protection
The Centre for Child Development and Education aims to support better outcomes in health, education and social emotional wellbeing.
-

Ears
Nine out of 10 young Indigenous children who live in remote communities have some form of ear disease.
-

-

Heart
Indigenous people are up to eight times more likely to be hospitalised and nearly 20 times as likely to die from Rheumatic Heart Disease.
-

Hygiene
Infection amongst Indigenous children living remotely is a major cause of recurrent clinic presentations, and hospitalisations.
-

Lungs
Lung conditions are the most common reason why Indigenous people see a doctor.
-

-

Vaccination
Menzies have a major focus on immunisation and vaccine-preventable diseases that affect Aboriginal and Torres Strait Islander children.
-